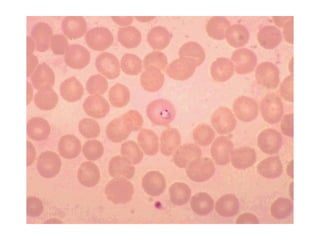
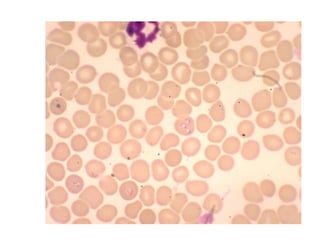

This document contains 15 clinical vignettes asking about appropriate diagnosis and management. The correct answers are provided after each question. Key themes include appropriate treatment for conditions like Lyme disease, fungal infections, meningitis, sexually transmitted infections, neutropenic infections, and rabies exposure.